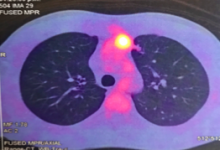

Embryonic Carcinoma of Anterior Mediastinum: Case Report [1]
Clinical Case
A 32-year-old man was referred with a diagnosis of an extragonadal germ cell tumor in the anterior mediastinum. Initially, he was treated with four cycles of chemotherapy (bleomycin, etoposide phosphate, and cisplatin), after which a PET-CT demonstrated a persistent hypermetabolic mass (SUV max 7.8) in the anterior mediastinum measuring 48 x 32 x 70 mm, without other metabolic abnormalities. Alpha-fetoprotein (AFP), LDH, and human chorionic gonadotrophin serum levels were normal. A radical surgical resection was recommended due to persistent residual disease. It was performed via a sternotomy with mediastinal tumor resection, pulmonary segmentectomy, and left diaphragm plication, due to resection of the involved phrenic nerve. The pathology results showed an embryonal carcinoma, 90 x 70 x 40 mm, with lung parenchyma involvement and 24% necrosis. There was no lymphovascular invasion, 1 of 4 lymph nodes had metastasis, and the margins were negative. Markers CD117 and CD30 were positive, AFP was negative. The patient recovered well. He was discussed in a tumor conference and was recommended to undergo adjuvant chemotherapy followed by bone marrow transplant.
PET – CT: Persistence of a hypermetabolic residual mass (SUV max 7.8) of 48 x 32 x 70 mm is observed in the anterior mediastinum.
Discussion
Of the nonseminomatous tumors of the mediastinum, embryonal carcinoma is the least frequent (represents 2%). Initially, treatment is with chemotherapy, mainly when the lesion is large. Surgery is reserved for residual masses. The most widely used approach is median sternotomy. Surgical mortality is 4%, varying according to the volume of the lung resection. Approximately 10% of patients have synchronous pulmonary metastases, and this approach allows for access to both lungs. In this case, the surgical resection was radical and complete. The prognosis of patients undergoing chemotherapy and radical treatment of the mass, whether residual or not, is favorable for survival. Patients who pathologically show persistent germ cell or nongerm cell cancer have poor but possible long-term survival, justifying an aggressive surgical approach in patients who are considered operable.


References
- Hakim A, Kamangar N. Masses of the Anterior Mediastinum. In: Medical Management of the Thoracic Surgery Patient. Elsevier. 2009.
- Vijayalakshmi S. Case report: primary embryonal carcinoma of the anterior mediastinum. J Dent Med Sci. 2015;14(9):51-52.
- Kesler KA, Rieger KM, Hammoud ZT, Kruler LE, Perkins SM, Turrentine MW, et al. A 25-year single institution experience with surgery for primary mediastinal nonseminomatous germ cell tumors. Ann Thorac Surg. 2008;85:371–378. [3]
- Wright CD, Kesler KA. Surgical techniques and outcomes for primary nonseminomatous germ cell tumors. Chest Surg Clin N Am. 2002;12:707–715. [4]
Disclaimer
The information and views presented on CTSNet.org represent the views of the authors and contributors of the material and not of CTSNet. Please review our full disclaimer page here [5].